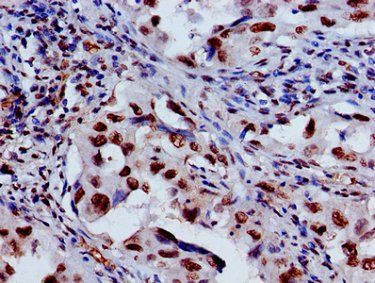
HIST1H3A Antibody

You have no items in your shopping cart.
Search results for: 'Histone H3'
- HIST1H3A Antibody [orb416509]
ChIP, ELISA, IF, IHC, WB
Human, Mouse
Rabbit
Polyclonal
Unconjugated
50 μl, 100 μl - HIST1H3A Antibody [orb416516]
ELISA, IF, IHC, WB
Human, Mouse, Rat
Rabbit
Polyclonal
Unconjugated
50 μl, 100 μl - HIST1H3A Antibody [orb416532]
ChIP, ELISA, IF, IHC, WB
Human, Mouse
Rabbit
Polyclonal
Unconjugated
100 μl, 50 μl - HIST1H3A Antibody [orb416456]
ChIP, ELISA, IF, IHC, WB
Human, Mouse
Rabbit
Polyclonal
Unconjugated
50 μl, 100 μl - HIST1H3A Antibody [orb416522]
ChIP, ELISA, IF, IHC, WB
Human
Rabbit
Polyclonal
Unconjugated
50 μl, 100 μl - HIST1H3A Antibody [orb416510]
ChIP, ELISA, IF, IHC, WB
Human, Mouse
Rabbit
Polyclonal
Unconjugated
50 μl, 100 μl - HIST1H3A Antibody [orb416485]
ChIP, ELISA, IF, IHC, WB
Human, Mouse
Rabbit
Polyclonal
Unconjugated
50 μl, 100 μl